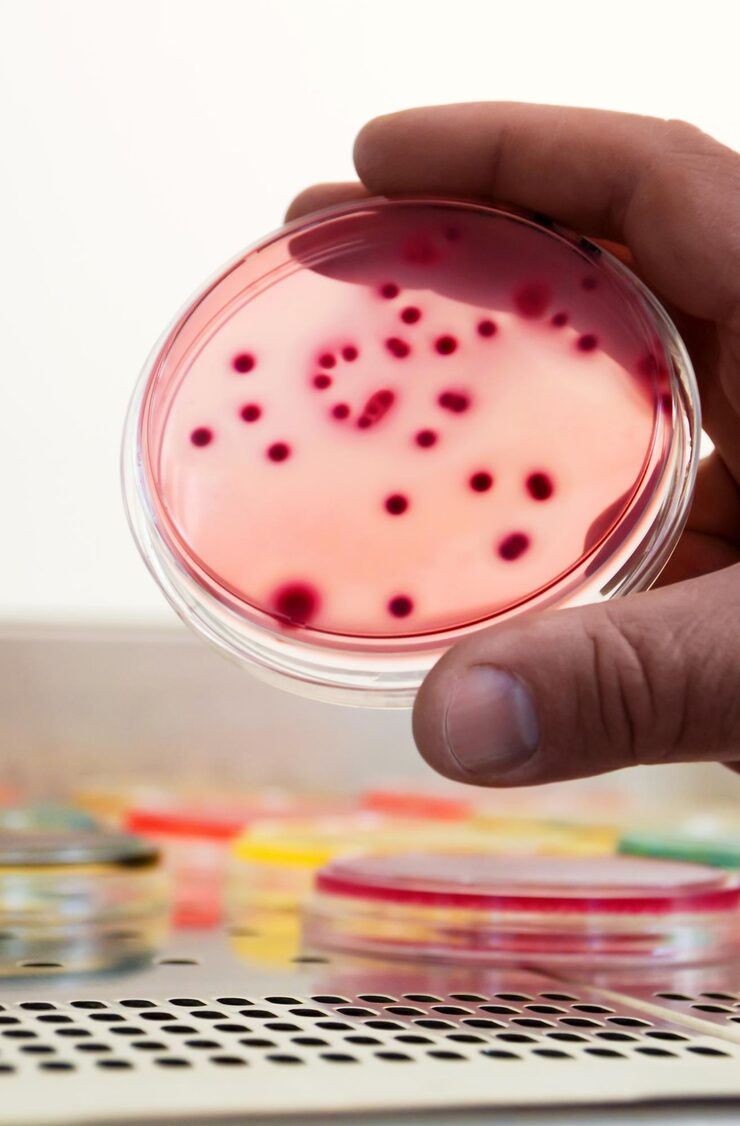

Intro
Our oncology trials investigate new cancer treatments, including immunotherapy, targeted drugs, and innovative diagnostics that aim to improve survival and quality of life.
Common Symptoms:
- Fatigue or pain
- Weight loss or appetite changes
- Swelling or abnormal growths
Current Treatments:
Surgery, chemotherapy, radiation, and targeted therapy are standard — but many patients can benefit from new investigational options under expert supervision.
